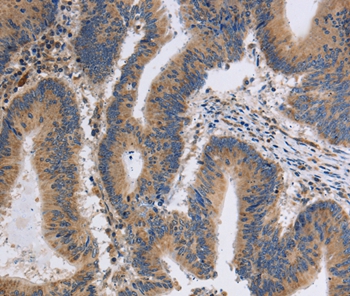

Anti-ITPR1 Antibody
144-07905
ApplicationsImmunoPrecipitation, Western Blot, ImmunoHistoChemistry
Product group Antibodies
TargetITPR1
Overview
- SupplierRayBiotech
- Product NameAnti-ITPR1 Antibody
- Delivery Days Customer16
- ApplicationsImmunoPrecipitation, Western Blot, ImmunoHistoChemistry
- CertificationResearch Use Only
- ClonalityPolyclonal
- ConjugateUnconjugated
- Gene ID3708
- Target nameITPR1
- Target descriptioninositol 1,4,5-trisphosphate receptor type 1
- Target synonymsACV, CLA4, INSP3R1, IP3R, IP3R1, PPP1R94, SCA15, SCA16, SCA29, inositol 1,4,5-trisphosphate-gated calcium channel ITPR1, IP3 receptor, IP3R 1, inositol 1,4,5 trisphosphate receptor, inositol 1,4,5-triphosphate receptor, type 1, protein phosphatase 1, regulatory subunit 94, type 1 InsP3 receptor, type 1 inositol 1,4,5-trisphosphate receptor
- HostRabbit
- IsotypeIgG
- Protein IDQ14643
- Protein NameInositol 1,4,5-trisphosphate receptor type 1
- Scientific DescriptionITPR1 Polyclonal Antibody
- Storage Instruction-20°C
- UNSPSC12352203